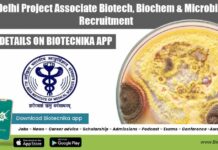
AIIMS Delhi Project Associate Biotech, Biochem & Microbiology Recruitment AIIMS Delhi Project Associate

Register For Python Basics Certification Course Exam – Check Exam Date
Python Certification Course Exam Schedule - Check Details
Dear Biotecnikans
This is an announcement for the students who attend the Python Basics Course Exclusively held in...
ICMR-NICED Immune Response Assessment of COVID Vaccine Project SRF For Life Sciences
NICED SRF Vacancy Available - Attend Walk-In-Interview
NICED SRF Vacancy Available - Attend Walk-In-Interview. Life Sciences Project Senior Research Fellow job opening at ICMR-NICED. ICMR-NICED...
Biotecnika Presents Shourya Batch for CSIR NET exam Preparation June 2022 & December 2022
Biotecnika Presents Shourya Batch for CSIR NET 2022 June & Dec
'चार बांस चौबीस गज अंगुल अष्ट प्रमाण।
ता ऊपर सुल्तान है, मत चूको चौहान।।
Remember this...
Biotecnika Newsletter 18.02.2022 Scientist Recruitment With Upto Rs. 1.77 Lakh pm Pay
Biotecnika Times - Scientist Recruitment With Upto Rs. 1.77 Lakh pm Pay
Inter University Accelerator Centre Scientist Recruitment With Up To Rs. 1.77 Lakh pm
Inter...
How Was The CSIR NET Exam? Participate In National CSIR NET Exam Survey –...
CSIR-NET Exam Discussion June-2021 - Request your feedback
Dear Biotecnikans
Finally, you are done! First of all many Congratulations! Woo hoo finally after 23 months you...
Internship Opportunity for Freshers @ BioTecNika in Molecular Biology Techniques, Check How to apply
Internship Opportunity for Freshers @ BioTecNika in Molecular Biology Techniques, Check How to apply
Molecular Biology Techniques Internship
If you don’t learn, then you won’t earn
Importance...
CIAB Fellowships For MSc/ MTech/ BE & BTech Biotech, Microbiology
CIAB Fellowships For MSc/ MTech/ BE & BTech Biotech, Microbiology
CIAB Fellowships For MSc/ MTech/ BE & BTech Biotech, Microbiology. MSc/ MTech/ BE & BTech...
IARI JRF & Young Professional Job Openings For Microbiology, Life Sciences, Biochemistry
IARI JRF & Young Professional Job Openings For Microbiology, Life Sciences, Biochemistry
IARI JRF & Young Professional Job Openings For Microbiology, Life Sciences, Biochemistry. MSc...
AIIMS Delhi Project Associate Biotech, Biochem & Microbiology Recruitment
AIIMS Delhi Project Associate Biotech, Biochem & Microbiology Recruitment
AIIMS Delhi Project Associate Biotech, Biochem & Microbiology Recruitment. Project Associate Microbiology/ Biotechnology/ Biochemistry job. Interested...
Govt BECIL PCM Recruitment, Online Application Process
Govt BECIL PCM Recruitment, Online Application Process
Govt BECIL PCM Recruitment, Online Application Process. Interested and eligible applicants can check out all of the details...
CSIR-IICB Sickle Cell Anemia Mission Project Job, Attend Walk-In
IICB Project Associate Vacancy Available - Biochem, Microbiology
IICB Project Associate Vacancy Available - Biochem, Microbiology. MSc Microbiology or Biochemistry. jobs for eligible candidates at...
Bangalore Bioinnovation Centre Collaborates With Cytiva For Aiding Indian Biopharma Ecosystem Through Homegrown Talent...
BBC Collaborating With Cytiva For Providing Training Programs
Aiding Indian biopharma ecosystem through homegrown talent pool
Bangalore Bioinnovation Centre collaborates with Cytiva to provide bioprocessing
training programs...
ICMR Delhi Non-Medical Scientist Recruitment With Rs. 51,000 pm Pay
ICMR Delhi Non-Medical Scientist Recruitment With Rs. 51,000 pm Pay
ICMR Delhi Non-Medical Scientist Recruitment With Rs. 51,000 pm Pay. MSc & PhD Life Sciences,...
10 Points to Keep In Mind Before You Go for the Exam – GOOD...
Last-Minute CSIR-NET Exam Tips - All the Best Dear Aspirants
Dear CSIR NET Aspirants,
Wow after a lot of tears of joy and happiness over the...
2023-2024 Fulbright-Nehru Master’s Fellowships
2023-2024 Fulbright-Nehru Master’s Fellowships
2023-2024 Fulbright-Nehru Master’s Fellowships. 2023-2024 Fulbright-Nehru Master’s Fellowships Notification. Fulbright-Nehru Master’s Fellowships For Indians 2023. Interested and eligible applicants can check...